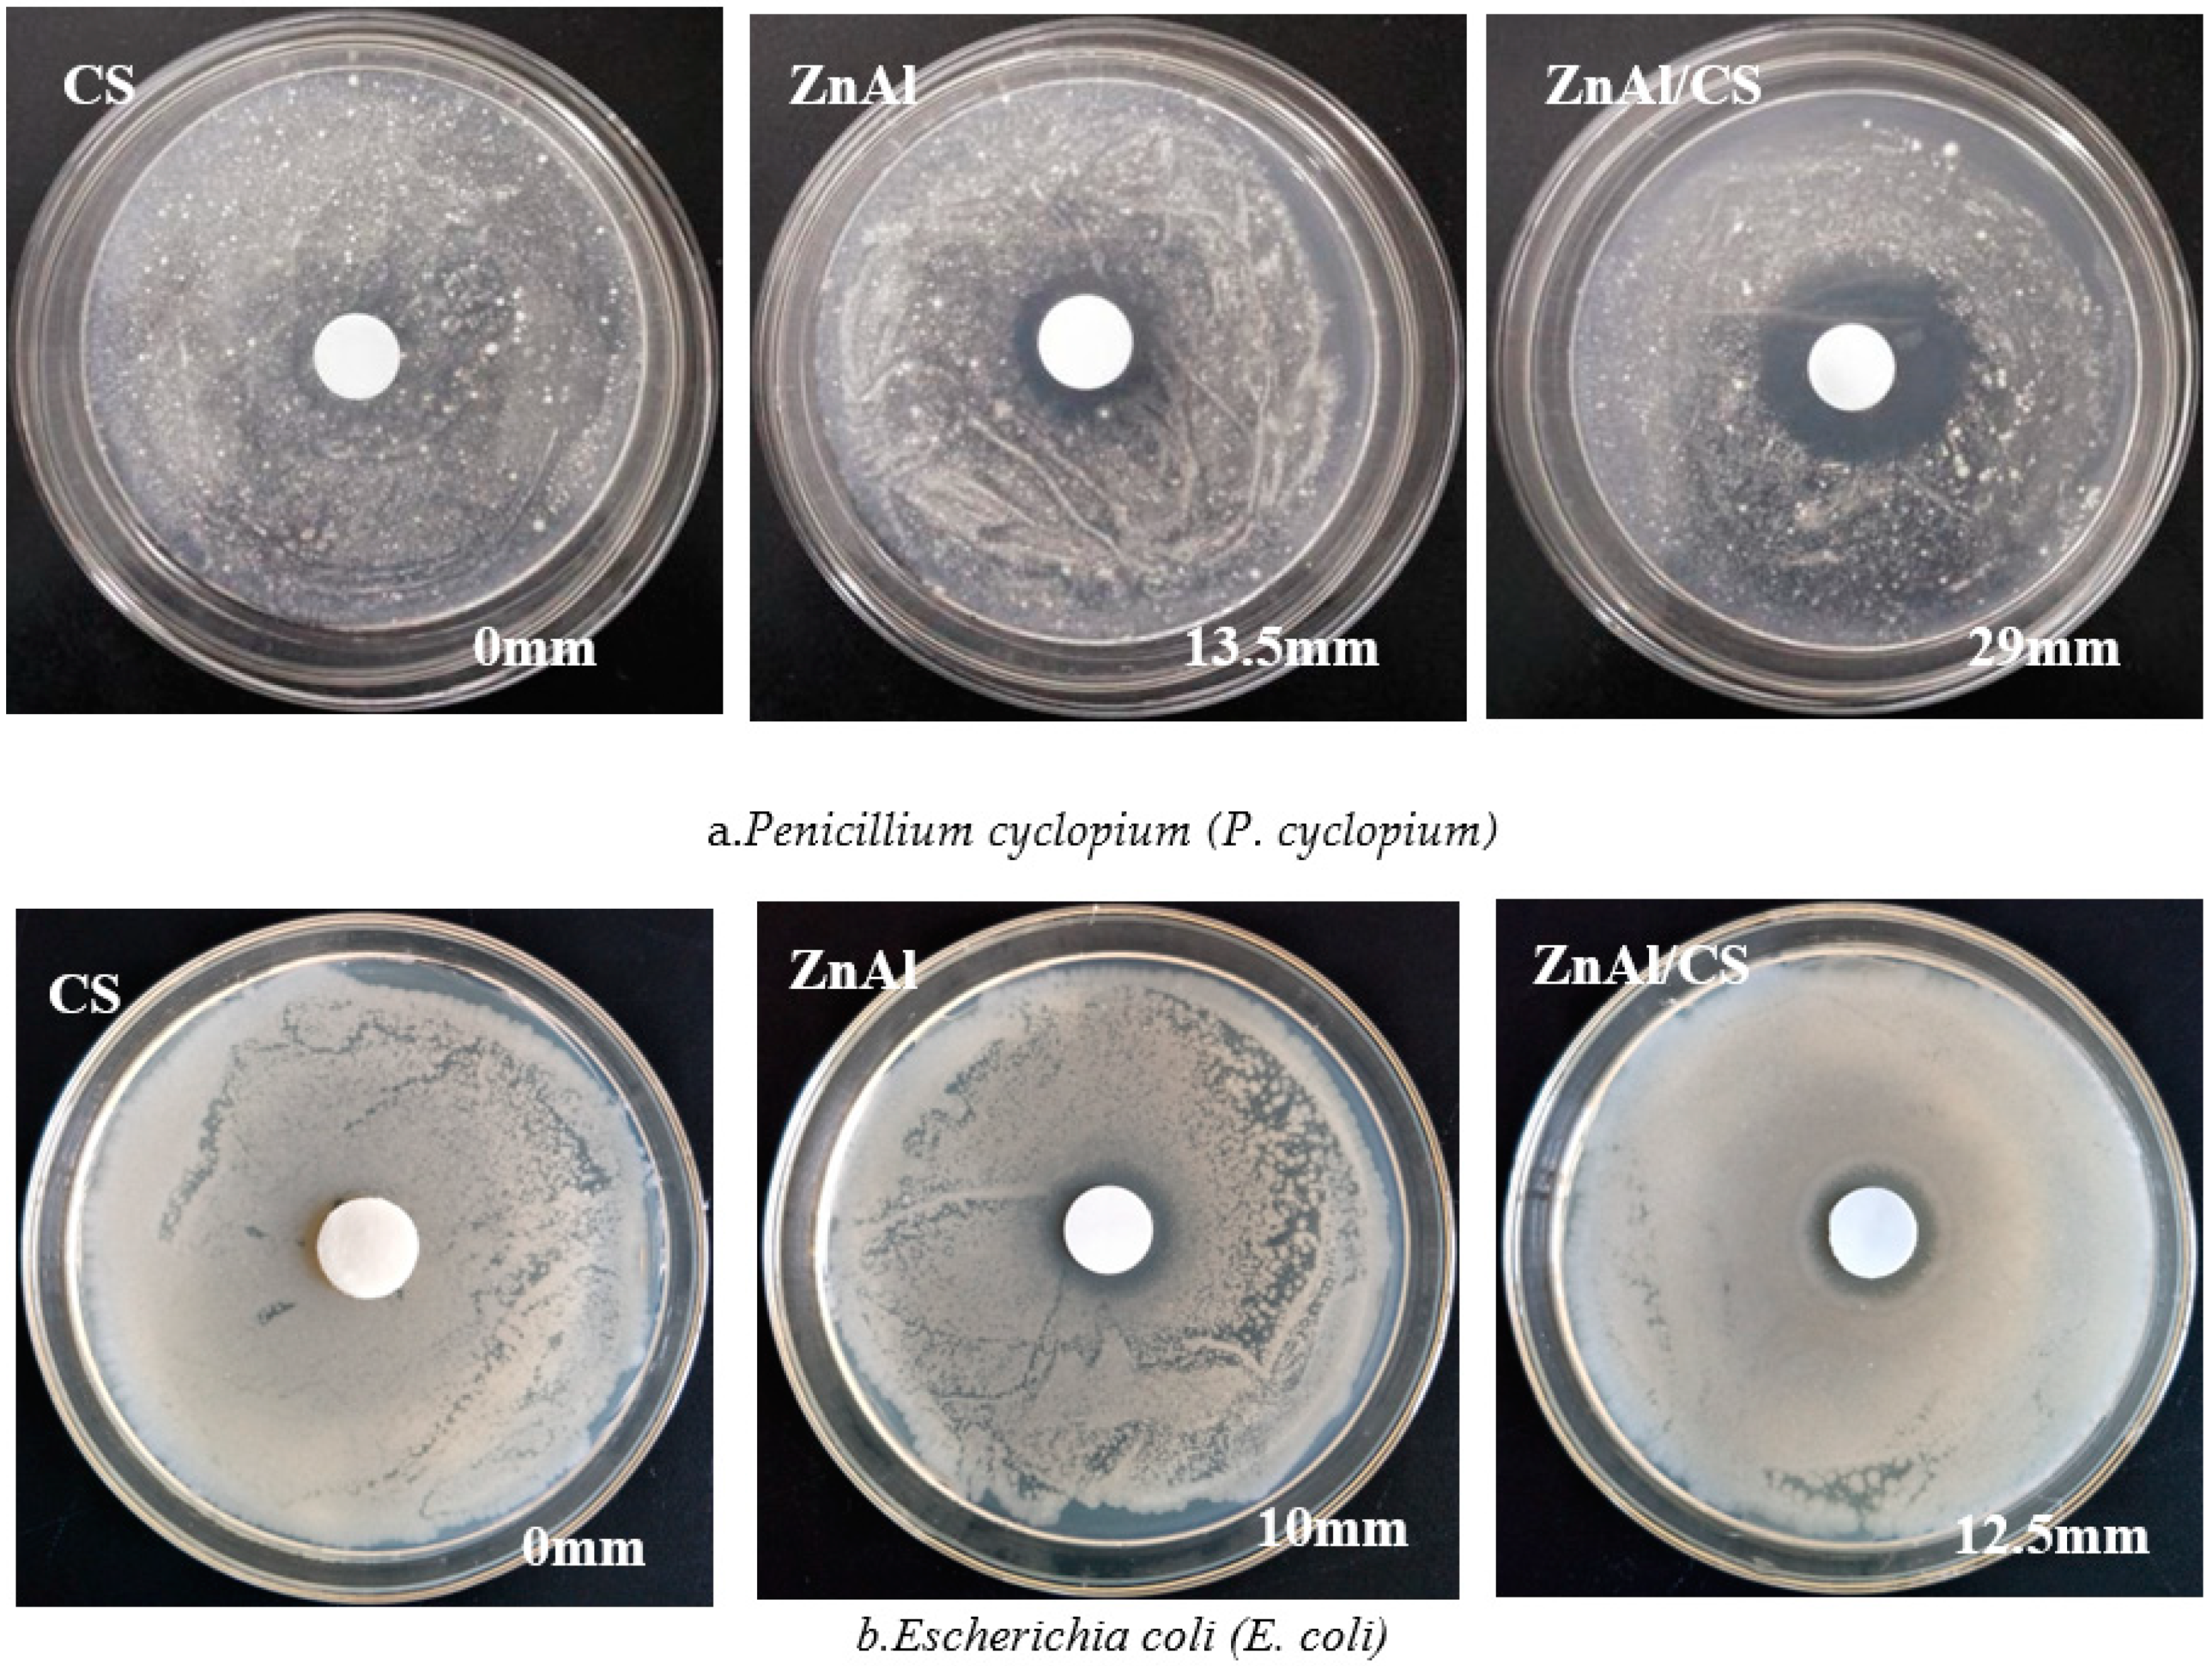
Ijms 20 05705 g007

Optimization of ZnAl/Chitosan Supra-Nano Hybrid Preparation as Efficient Antibacterial Material
Abstract
1. Introduction
2. Results and Discussions
2.1. FT-IR Spectroscopy Analysis
2.2. Thermal Analysis (TGA/DTG)
2.3. UV–Vis Spectroscopy Analysis
2.4. XRD Analysis
2.5. SEM Analysis
2.6. Antimicrobial Activity Study
2.7. Optimization by Response Surface Methodology
2.7.1. Data Analysis and Evaluation of CCD Model
Main Effects of the Independent Variables P (Initial pH), R (Ratio ZnAl), and C (CS Concentration (g/L)) and Interactions between Parameters
2.7.2. Optimization Analysis
2.8. Antibacterial Killing Kinetic Assays of ZnAl/CS
3. Materials and Methods
3.1. Materials
3.2. Preparation of ZnAl-LDH and ZnAl/CS

3.3. FT-IR Spectroscopy Analysis
3.4. Thermal Analysis (TGA/DTG)
3.5. UV-vis Spectroscopy Analysis
3.6. XRD Analysis
3.7. SEM Analysis
3.8. Organism and Culture Conditions
In Vitro Antibacterial Activity
3.9. Optimization of ZnAl/CS Hybrid Preparation Conditions
3.10. Kinetic Study
3.11. Statistical Analysis
4. Conclusions
Author Contributions
Funding
Conflicts of Interest
References
- Sharaha, U.; Rodriguez-Diaz, E.; Riesenberg, K.; Bigio, I.J.; Huleihel, M.; Salman, A. Using Infrared Spectroscopy and Multivariate Analysis to Detect Antibiotics’ Resistant Escherichia coli Bacteria. Anal. Chem. 2017, 89, 8782–8790. [Google Scholar] [CrossRef] [PubMed]
- Belete, T.M. Novel targets to develop new antibacterial agents and novel alternatives to antibacterial agents. Hum. Microbiome J. 2019, 11, 100052. [Google Scholar] [CrossRef]
- Palla-Rubio, B.; Araújo-Gomes, N.; Fernández-Gutiérrez, M.; Rojo, L.; Suay, J.; Gurruchaga, M.; Goñi, I. Synthesis and characterization of silica-chitosan hybrid materials as antibacterial coatings for titanium implants. Carbohydr. Polym. 2019, 203, 331–341. [Google Scholar] [CrossRef]
- Mulongo-Masamba, R.; Hamidi, A.E.; Bouyahya, A.; Halim, M.; Arsalane, S. A novel hybrid β-chitin/calcium phosphate functionalized with copper nanoparticles for antibacterial applications. J. Environ. Chem. Eng. 2018, 6, 6399–6406. [Google Scholar] [CrossRef]
- Patil, P.P.; Bohara, R.A.; Meshram, J.V.; Nanaware, S.G.; Pawar, S.H. Hybrid chitosan-ZnO nanoparticles coated with a sonochemical technique on silk fibroin-PVA composite film: A synergistic antibacterial activity. Int. J. Biol. Macromol. 2019, 122, 1305–1312. [Google Scholar] [CrossRef]
- Rokesh, K.; Sakar, M. Trong-OnDo, 2-(Aminomethyl pyridine)SbI5: An emerging visible-light driven organic-inorganic hybrid perovskite for photoelectrochemical and photocatalytic applications. Mater. Lett. 2019, 242, 99–102. [Google Scholar] [CrossRef]
- Zhou, D.; Wang, Y.; Zhu, J.; Yu, J.; Hu, Z. Mechanically strong and highly efficient healable organic/inorganic hybrid dynamic network. Polymer 2019, 167, 202–208. [Google Scholar] [CrossRef]
- Manchand, H.; Mannari, V. Super photo-base initiated organic-inorganic hybrid coatings by plural-cure mechanisms. Prog. Org. Coat. 2019, 127, 222–230. [Google Scholar] [CrossRef]
- Cunha, V.R.R.; Guilherme, V.A.; De Paula, E.; De Araujo, D.R.; Silva, R.O.; Medeiros, J.V.R.; Leite, J.R.S.A.; Peterson, P.A.D.; Foldvari, M.; Petrilli, H.M.; et al. Delivery system for mefenamic acid based on the nanocarrier layered double hydroxide: Physicochemical characterization and evaluation of anti-inflammatory and antinociceptive potential. Mater. Sci. Eng. C 2016, 58, 629–638. [Google Scholar] [CrossRef]
- Yuab, S.; Xu, X.; Feng, J.; Liu, M.; Hu, K. Chitosan and chitosan coating nanoparticles for the treatment of brain disease. Int. J. Pharm. 2019, 560, 282–293. [Google Scholar]
- Vakili, M.; Rafatullah, M.; Salamatinia, B.; Abdullah, A.Z.; Ibrahim, M.H.; Tan, K.B.; Gholami, Z.; Amouzgar, P. Application of chitosan and its derivatives as adsorbents for dye removal from water and wastewater: A review. Carbohyd. Polym. 2014, 113, 115–130. [Google Scholar] [CrossRef] [PubMed]
- Omidi, S.; Kakanejadifard, A. Modification of chitosan and chitosan nanoparticle by long chain pyridinium compounds: Synthesis, characterization, antibacterial, and antioxidant activities. Carbohydr. Polym. 2019, 208, 477–485. [Google Scholar] [CrossRef] [PubMed]
- Wang, X.J.; Lou, T.; Zhao, W.H.; Song, G.J. Preparation of pure chitosan film using ternary solvents and its super absorbency. Carbohydr. Polym. 2016, 153, 253–257. [Google Scholar] [CrossRef] [PubMed]
- Ge, H.C.; Hua, T.T. Synthesis and characterization of poly (maleic acid)-grafted crosslinked chitosan nanomaterial with high uptake and selectivity for Hg (II) sorption. Carbohydr. Polym. 2016, 153, 246–252. [Google Scholar] [CrossRef]
- Zubair, M.; Daud, M.; McKay, G.; Shehzad, F.; Al-Harthi, M.A. Recent progress in layered double hydroxides (LDH)-containing hybrids as adsorbents for water remediation. Appl. Clay Sci. 2017, 143, 279–292. [Google Scholar] [CrossRef]
- Verlee, A.; Mincke, S.; Stevens, C.V. Review: Recent developments in antibacterial and antifungal chitosan and its derivatives. Carbohydr. Polym. 2017, 164, 268–283. [Google Scholar] [CrossRef]
- Thomas, V.; Yallapu, M.M.; Sreedhar, B.; Bajpai, S.K. Fabrication, characterization of chitosan/nanosilver film and its potential antibacterial application. J. Biomater. Sci. Polym. E 2009, 20, 2129–2144. [Google Scholar] [CrossRef]
- Chien, R.C.; Yen, M.T.; Mau, J.L. Antimicrobial and antitumor activities of chitosan from shiitake stipes, compared to commercial chitosan from crab shells. Carbohydr. Polym. 2016, 138, 259–264. [Google Scholar] [CrossRef]
- Choi, C.; Nam, J.P.; Nah, J.W. Application of chitosan and chitosan derivatives as biomaterials. J. Ind. Eng. Chem. 2016, 33, 1–10. [Google Scholar] [CrossRef]
- Murugadoss, A.; Chattopadhyay, A. A “green” chitosan-silver nanoparticle composite as a heterogeneous as well as micro-heterogeneous catalyst. Nanotechnology 2008, 19, 015603. [Google Scholar] [CrossRef]
- Ruiz-Hitzky, E.; Aranda, P.; Darder, M.; Rytwo, G. Hybrid materials based on clays for environmental and biomedical applications. J. Mater. Chem. 2010, 20, 9306–9321. [Google Scholar] [CrossRef]
- FAO. Food Chain Crisis Management Framework. In Preventing E. coli in Food; FAO: Rome, Italy, 2011; Available online: www.fao.org/foodchain (accessed on 23 July 2014).
- Kaper, J.B.; Nataro, J.P.; Mobley, H.L.T. Pathogenic Escherichia coli. Nat. Rev. Microbiol. 2004, 2, 123–140. [Google Scholar] [CrossRef] [PubMed]
- Mishra, G.; Dash, B.; Pandey, S.; Mohanty, P.P. Antibacterial actions of silver nanoparticles incorporated Zn-Al layered double hydroxide and its spinel. J. Environ. Chem. Eng. 2013, 1, 1124–1130. [Google Scholar] [CrossRef]
- Li, B.; Zhang, Y.; Yang, Y.; Qiu, W.; Wang, X.X.; Liu, B.P.; Wang, Y.L.; Sun, G.C. Synthesis, characterization, and antibacterial activity of chitosan/TiO2 nanocomposite against Xanthomonas oryzae pv. oryzae. Carbohydr. Polym. 2016, 152, 825–831. [Google Scholar] [CrossRef]
- Depan, D.; Singh, R.P. Preparation and Characterization of Novel Hybrid of Bio-Assisted Mineralized Zn-Al Layered Double Hydroxides Using Chitosan as a Template. J. Appl. Polym. Sci. 2010, 115, 3636–3644. [Google Scholar] [CrossRef]
- Gohi, B.F.C.A.; Zeng, H.Y.; Cao, X.J.; Zou, K.M.; Shuai, W.; Diao, Y. Preparation of the Hybrids of Hydrotalcites and Chitosan by Urea Method and Their Antimicrobial Activities. Polymers 2019, 11, 1588. [Google Scholar] [CrossRef] [PubMed]
- Ballarin, B.; Mignani, A.; Mogavero, F.; Gabbanini, S.; Morigi, M. Hybrid material based on ZnAl hydrotalcite and silver nanoparticles for deodorant formulation. Appl. Clay Sci. 2015, 114, 303–308. [Google Scholar] [CrossRef]
- Gohi, B.; Zeng, H.Y.; Pan, A.D. Optimization and Characterization of Chitosan Enzymolysis by Pepsin. Bioengineering 2016, 3, 17. [Google Scholar] [CrossRef] [PubMed]
- Valentin, R.; Bonelli, B.; Garrone, E.; Renzo, D.F.; Quignard, F.O. Accessibility of the Functional Groups of Chitosan Aerogel Probed by FT-IR-Monitored Deuteration. Biomacromolecules 2007, 8, 3646–3650. [Google Scholar] [CrossRef]
- Saber, O.; Tagaya, H. Preparation and Intercalation Reactions of Zn-Sn LDH and Zn-Al-Sn LDH. J. Porous Mater. 2003, 10, 83–91. [Google Scholar] [CrossRef]
- Sifontes, A.B.; Gonzalez, G.; Ochoa, J.L.; Tovar, L.M.; Zoltan, T.; Cañizales, E. Chitosan as template for the synthesis of ceria nanoparticles. Mater. Res. Bull. 2011, 46, 1794–1799. [Google Scholar] [CrossRef]
- Chen, Y.F.; Zhou, S.H.; Li, F.; Chen, Y.W. Synthesis and photoluminescence of Eu-doped Zn/Al layered double hydroxides. J. Mater. Sci. 2010, 45, 6417. [Google Scholar] [CrossRef]
- Braga, T.P.; Longhinotti, E.; Pinheiro, A.N.; Valentini, A. Synthesis of hybrid spheres for the dehydrogenation of ethylbenzene in the presence of CO2. Appl. Catal. A Gen. 2009, 362, 139–146. [Google Scholar] [CrossRef]
- Cardenas, G.; Miranda, S.P. FTIR and TGA Studies of chitosan composite films. J. Chil. Chem. Soc. 2004, 49, 291–295. [Google Scholar] [CrossRef]
- Kumar, S.; Koh, J. Physiochemical, optical and biological activity of chitosan-chromone derivative for biomedical applications. Int. J. Mol. Sci. 2012, 13, 6102–6116. [Google Scholar] [CrossRef]
- Taboada, E. Retención de Metales Pesados Utilizando Quitosano y Derivados. Ph.D. Thesis, Universidad de Concepción, Concepción, Chile, January 2003. [Google Scholar]
- Hajibeygi, M.; Shabanian, M.; Khonakdar, H.A. Zn-AL LDH reinforced nanocomposites based on new polyamide containing imide group: From synthesis to properties. Appl. Clay Sci. 2015, 114, 256. [Google Scholar] [CrossRef]
- Chen, Y.F.; Wang, X.Q.; Luo, S.D.; Bao, Y. Synthesis of new Tb-doped Zn-Al LDH/tryptophan hybrids and their fluorescent property. J. Rare Earth. 2016, 34, 1095. [Google Scholar] [CrossRef]
- Ahuja, M.; Bhatt, D.C. Polyelectrolyte complex of carboxymethyl gum katira-chitosan: Preparation and characterization. Int. J. Biol. Macromol. 2018, 106, 1184–1191. [Google Scholar]
- Elhalil, A.; Elmoubarki, R.; Machrouhia, A.; Sadiq, M.; Abdennouri, M.; Qourzal, S.; Barka, N. Photocatalytic degradation of caffeine by ZnO-ZnAl2O4 nanoparticles derived from LDH structure. J. Environ. Chem. Eng. 2017, 5, 3719–3726. [Google Scholar] [CrossRef]
- Ahmed, A.A.A.; Talib, Z.A.; Hussein, M.Z.B. Thermal, optical and dielectric properties of Zn-Al layered double hydroxide. Appl. Clay Sci. 2012, 56, 68–76. [Google Scholar] [CrossRef]
- Kumirska, J.; Czerwicka, M.; Kaczyński, Z.; Bychowska, A.; Brzozowski, K.; Thöming, J.; Stepnowski, P. Application of Spectroscopic Methods for Structural Analysis of Chitin and Chitosan. Mar. Drugs. 2010, 8, 1567–1636. [Google Scholar] [CrossRef] [PubMed]
- Chai, H.; Lin, Y.; Evans, D.G.; Li, D. Synthesis and UV absorption properties of 2-naphthylamine-1, 5-disulfonic acid intercalated Zn−Al layered double hydroxides. Ind. Eng. Chem. Res. 2008, 47, 2855–2860. [Google Scholar] [CrossRef]
- Zhang, Y.Q.; Xue, C.H.; Xue, Y.; Gao, R.C.; Zhang, X.L. Determination of the degree of deacetylation of chitin and chitosan by X-ray powder diffraction. Carbohydr. Res. 2005, 340, 1914–1917. [Google Scholar] [CrossRef] [PubMed]
- Yen, M.T.; Mau, J.L. Physico-chemical characterization of fungal chitosan from shiitake stipes. LWT-Food. Sci. Technol. 2007, 40, 472–479. [Google Scholar] [CrossRef]
- Bangyekan, C.; Aht-Ong, D.; Srikulkit, K. Preparation and properties evaluation of chitosan-coated cassava starch films. Carbohydr. Polym. 2006, 63, 61–71. [Google Scholar] [CrossRef]
- Prashanth, K.V.H.; Tharanathan, R.N. Studies on graft copolymerization of chitosan with synthetic monomers. Carbohydr. Polym. 2003, 53, 343–351. [Google Scholar] [CrossRef]
- Tzompantzi, F.; Mantilla, A.; Banuelos, F.; Fernandez, J.L.; Gomez, R. Improved Photocatalytic Degradation of Phenolic Compounds With ZnAl Mixed Oxides Obtained from LDH Materials. Top. Catal. 2011, 54, 257–263. [Google Scholar] [CrossRef]
- Xue, X.Y.; Zhang, S.H.; Zhang, H.G. Structures of LDHs Intercalated with Ammonia and the Thermal Stability for Poly (vinyl chloride). Am. J. Anal. Chem. 2015, 6, 334–341. [Google Scholar] [CrossRef][Green Version]
- Bonev, B.; Hooper, J.; Parisot, J. Principles of assessing bacterial susceptibility to antibiotics using the agar diffusion method. J. Antimicrob. Chemother. 2008, 61, 1295–1301. [Google Scholar] [CrossRef]
- Kulikov, S.N.; Chirkov, S.N.; Il’ina, A.V.; Lopatin, S.A.; Varlamov, V.P. Effect of the molecular weight of chitosan on its antiviral activity in plants. Prik. Biokhim. Mikrobiol. 2006, 42, 224–228. [Google Scholar] [CrossRef]
- Jia, Z.; shen, D.; Xu, W. Synthesis and antibacterial activities of quaternary ammonium salt of chitosan. Carbohydr. Res. 2001, 333, 1–6. [Google Scholar] [CrossRef]
- Li, M.; Sultanbawa, Y.; Xu, Z.P.; Gu, W.; Chen, W.; Liu, J.; Qian, G. High and long-term antibacterial activity against Escherichia coli via synergy between the antibiotic penicillin G and its carrier ZnAl layered double hydroxide. Colloid. Surf. B 2018, 174, 435–442. [Google Scholar] [CrossRef] [PubMed]
- Velázquez-Herrera, F.D.; Fetter, G.; Rosato, V.; Pereyra, A.M.; Basaldella, E.I. Effect of structure, morphology and chemical composition of Zn-Al, Mg/ZnAl and Cu/Zn-Al hydrotalcites on their antifungal activity against A. niger. J. Environ. Chem. Eng. 2018, 6, 3376–3383. [Google Scholar] [CrossRef]
- Mishra, G.; Dash, B.; Pandey, S.; Sethi, D.; Kumar, C.G. Comparative Evaluation of Synthetic Routes and Antibacterial/Antifungal Properties of Zn–Al Layered Double Hydroxides Containing Benzoate Anion. Environ. Eng. Sci. 2017, 35. [Google Scholar] [CrossRef]
- Li, M.; Zhu, L.; Lin, D. Toxicity of ZnO nanoparticles to Escherichia coli: Mechanism and the influence of medium components. Environ. Sci. Technol. 2011, 45, 1977–1983. [Google Scholar] [CrossRef]
- Colinas, I.R.; Rojas-Andrade, M.D.; Chakraborty, I.; Oliver, S.R.J. Two structurally diverse Zn-based coordination polymers with excellent antibacterial activity. CrystEngComm 2018, 24, 14. [Google Scholar] [CrossRef]
- Zou, Y.H.; Wang, J.; Cui, L.Y.; Cui, R.C.; Wang, Q.Z.; Han, Q.X.; Qiu, J.; Chen, X.B.; Chen, D.C.; Chen, S.K.; et al. Corrosion resistance and antibacterial activity of zinc-loaded montmorillonite coatings on biodegradable magnesium alloy AZ31. Acta Biomater. 2019, 98, 196. [Google Scholar] [CrossRef]
- Bahrani, S.; Hashemi, S.A.; Mousavi, S.M.; Azhdari, R. Zinc-based metal-organic frameworks as nontoxic and biodegradable platforms for biomedical applications: Review study. Drug Metab. Rev. 2019, 51, 356. [Google Scholar] [CrossRef]
- Pasquet, J.; Chevalier, Y.; Pelletier, J.; Couval, E.; Bouvier, D.; Bolzinger, M.A. The contribution of zinc ions to the antimicrobial activity of zinc oxide. Colloids Surf. A Phys. Eng. Asp. 2014, 457, 263–274. [Google Scholar] [CrossRef]
- Chang, A.K.T.; Frias, R.R., Jr.; Alvarez, L.V.; Bigol, U.G.; Guzman, J.P.M.D. Comparative antibacterial activity of commercial chitosan and chitosan extracted from Auricularia sp. Biocatal. Agric. Biotechnol. 2019, 17, 189–195. [Google Scholar] [CrossRef]
- No, H.K.; Park, N.Y.; Park, S.H.; Meyers, S.P. Antibacterial activity of chitosans and chitosan oligomers with different molecular weights. Int. J. Food. Microbiol. 2002, 74, 65–72. [Google Scholar] [CrossRef]
- Andres, Y.; Giraud, L.; Gerente, C.; Le Cloirec, P. Antibacterial Effects of Chitosan Powder: Mechanisms of action. Environ. Technol. 2007, 28, 1357–1363. [Google Scholar] [CrossRef] [PubMed]
- Tanyildizi, M.S.; Özer, D.; Elibol, M. Optimization of α-amylase production by Bacillus sp. using responsesurface methodology. Process Biochem. 2005, 40, 2291–2296. [Google Scholar] [CrossRef]
- Zeng, H.Y.; Deng, X.; Deng, Y.J.; Liao, K.B. Preparation of Mg-Al Hydrotalcite by Urea Method and Its Catalytic Activity for Transesterification. AIChE J. 2009, 55, 1229–1235. [Google Scholar] [CrossRef]
- Liao, E.I.; Minussi, F.B.; Da Cruz, C.C.T.; Bernardi, A.C.C.; Ribeiro, C. Urea-Montmorillonite-Extruded Nanocomposites: A Novel Slow-Release Material. J. Agric. Food Chem. 2012, 60, 5267–5272. [Google Scholar]
- Chi, Y.S.; Shu-ning, W.S. Influence of Different Al Resources and Preparation Methods on the Synthesis of Mg-Al Hydrotalcite-like Compounds. Plast. Addit. 2008, 6, 25–28. [Google Scholar]
- Park, K.S.; Kang, K.T.; Lee, S.B.; Kim, G.Y.; Park, Y.J.; Kim, H.G. Synthesis of LiFePO4 with fine particle by co-precipitation method. Mater. Res. Bull. 2004, 39, 1803–1810. [Google Scholar] [CrossRef]
- Bredin, J.; Regli, A.D.; Pages, J.M. Propyl paraben induces potassium efflux in Escherichia coli. J. Antimicrob. Chemother. 2005, 55, 1013–1015. [Google Scholar] [CrossRef]
- Schaechter, M.; Maaløe, O.; Kjeldgaard, N.O. Dependence on medium and temperature of cell size and chemical composition during balanced growth of Salmonella typhimurium. J. Gen. Microbiol. 1958, 19, 592–602. [Google Scholar] [CrossRef]

| Run | Experimental Variables | Response Y (mm) | |||
|---|---|---|---|---|---|
| P | R | C(g/L) | Expt. | Predicted | |
| 1 | 11.00 | 3.00 | 1.00 | 16.7 | 16.60 |
| 2 | 9.00 | 1.00 | 0.50 | 5.9 | 5.91 |
| 3 | 11.00 | 3.00 | 1.00 | 17 | 16.60 |
| 4 | 11.00 | 3.00 | 1.00 | 16.5 | 16.60 |
| 5 | 11.00 | 3.00 | 1.84 | 15.8 | 15.57 |
| 6 | 9.00 | 5.00 | 1.50 | 10.3 | 10.44 |
| 7 | 11.00 | −0.36 | 1.00 | 3.1 | 3.02 |
| 8 | 13.00 | 5.00 | 1.50 | 14.6 | 14.69 |
| 9 | 13.00 | 1.00 | 0.50 | 8.3 | 8.27 |
| 10 | 13.00 | 5.00 | 0.50 | 11 | 11.37 |
| 11 | 7.64 | 3.00 | 1.00 | 5.1 | 5.44 |
| 12 | 11.00 | 3.00 | 0.16 | 13.2 | 13.26 |
| 13 | 11.00 | 6.36 | 1.00 | 10 | 9.91 |
| 14 | 9.00 | 5.00 | 0.50 | 9.2 | 8.82 |
| 15 | 11.00 | 3.00 | 1.00 | 16.4 | 16.60 |
| 16 | 11.00 | 3.00 | 1.00 | 16 | 16.60 |
| 17 | 14.36 | 3.00 | 1.00 | 11.5 | 10.99 |
| 18 | 9.00 | 1.00 | 1.50 | 5.6 | 5.34 |
| 19 | 13.00 | 1.00 | 1.50 | 8.9 | 9.39 |
| 20 | 11.00 | 3.00 | 1.00 | 17 | 16.60 |
| Source | Sum of Squares | DF | Mean Square | F | p-Value |
|---|---|---|---|---|---|
| Model | 389.68 | 9 | 43.30 | 239.77 | <0.0001 |
| P | 37.28 | 1 | 37.28 | 206.44 | <0.0001 |
| R | 57.42 | 1 | 57.42 | 318.00 | <0.0001 |
| C | 6.43 | 1 | 6.43 | 35.62 | 0.0001 |
| PR | 0.020 | 1 | 0.020 | 0.11 | 0.7462 |
| PC | 1.44 | 1 | 1.44 | 8.00 | 0.0179 |
| RC | 2.42 | 1 | 2.42 | 13.40 | 0.0044 |
| P2 | 126.70 | 1 | 126.70 | 701.61 | <0.0001 |
| R2 | 185.09 | 1 | 185.09 | 1024.96 | <0.0001 |
| C2 | 8.61 | 1 | 8.61 | 47.69 | <0.0001 |
| Residual | 1.81 | 10 | 0.18 | ||
| Lack of Fit | 1.07 | 5 | 0.21 | 1.44 | 0.3493 |
| Pure Error | 0.74 | 5 | 0.15 | ||
| Core Total | 391.49 | 19 | |||
| R2 | 0.9954 | ||||
| Adjusted R2 | 0.9912 | ||||
| Predicted R2 | 0.9753 | ||||
| Adequate precision | 45.211 | ||||
| CV | 3.66 |
| Independent Variables | Symbols | Units | Code Levels | ||
|---|---|---|---|---|---|
| −1 | 0 | +1 | |||
| pH | P | 9 | 11 | 13 | |
| Ratio Zn/Al | R | 1 | 3 | 5 | |
| Chitosan concentration | C | g/L | 0.50 | 1.00 | 1.50 |
© 2019 by the authors. Licensee MDPI, Basel, Switzerland. This article is an open access article distributed under the terms and conditions of the Creative Commons Attribution (CC BY) license (http://creativecommons.org/licenses/by/4.0/).
Share and Cite
Gohi, B.F.C.A.; Zeng, H.-Y.; Xu, S.; Zou, K.-M.; Liu, B.; Huang, X.L.; Cao, X.-J. Optimization of ZnAl/Chitosan Supra-Nano Hybrid Preparation as Efficient Antibacterial Material. Int. J. Mol. Sci. 2019, 20, 5705. https://doi.org/10.3390/ijms20225705
Gohi BFCA, Zeng H-Y, Xu S, Zou K-M, Liu B, Huang XL, Cao X-J. Optimization of ZnAl/Chitosan Supra-Nano Hybrid Preparation as Efficient Antibacterial Material. International Journal of Molecular Sciences. 2019; 20(22):5705. https://doi.org/10.3390/ijms20225705
Chicago/Turabian StyleGohi, Bi Foua Claude Alain, Hong-Yan Zeng, Sheng Xu, Kai-Min Zou, Binyao Liu, Xiu Li Huang, and Xiao-Ju Cao. 2019. "Optimization of ZnAl/Chitosan Supra-Nano Hybrid Preparation as Efficient Antibacterial Material" International Journal of Molecular Sciences 20, no. 22: 5705. https://doi.org/10.3390/ijms20225705
APA StyleGohi, B. F. C. A., Zeng, H.-Y., Xu, S., Zou, K.-M., Liu, B., Huang, X. L., & Cao, X.-J. (2019). Optimization of ZnAl/Chitosan Supra-Nano Hybrid Preparation as Efficient Antibacterial Material. International Journal of Molecular Sciences, 20(22), 5705. https://doi.org/10.3390/ijms20225705
